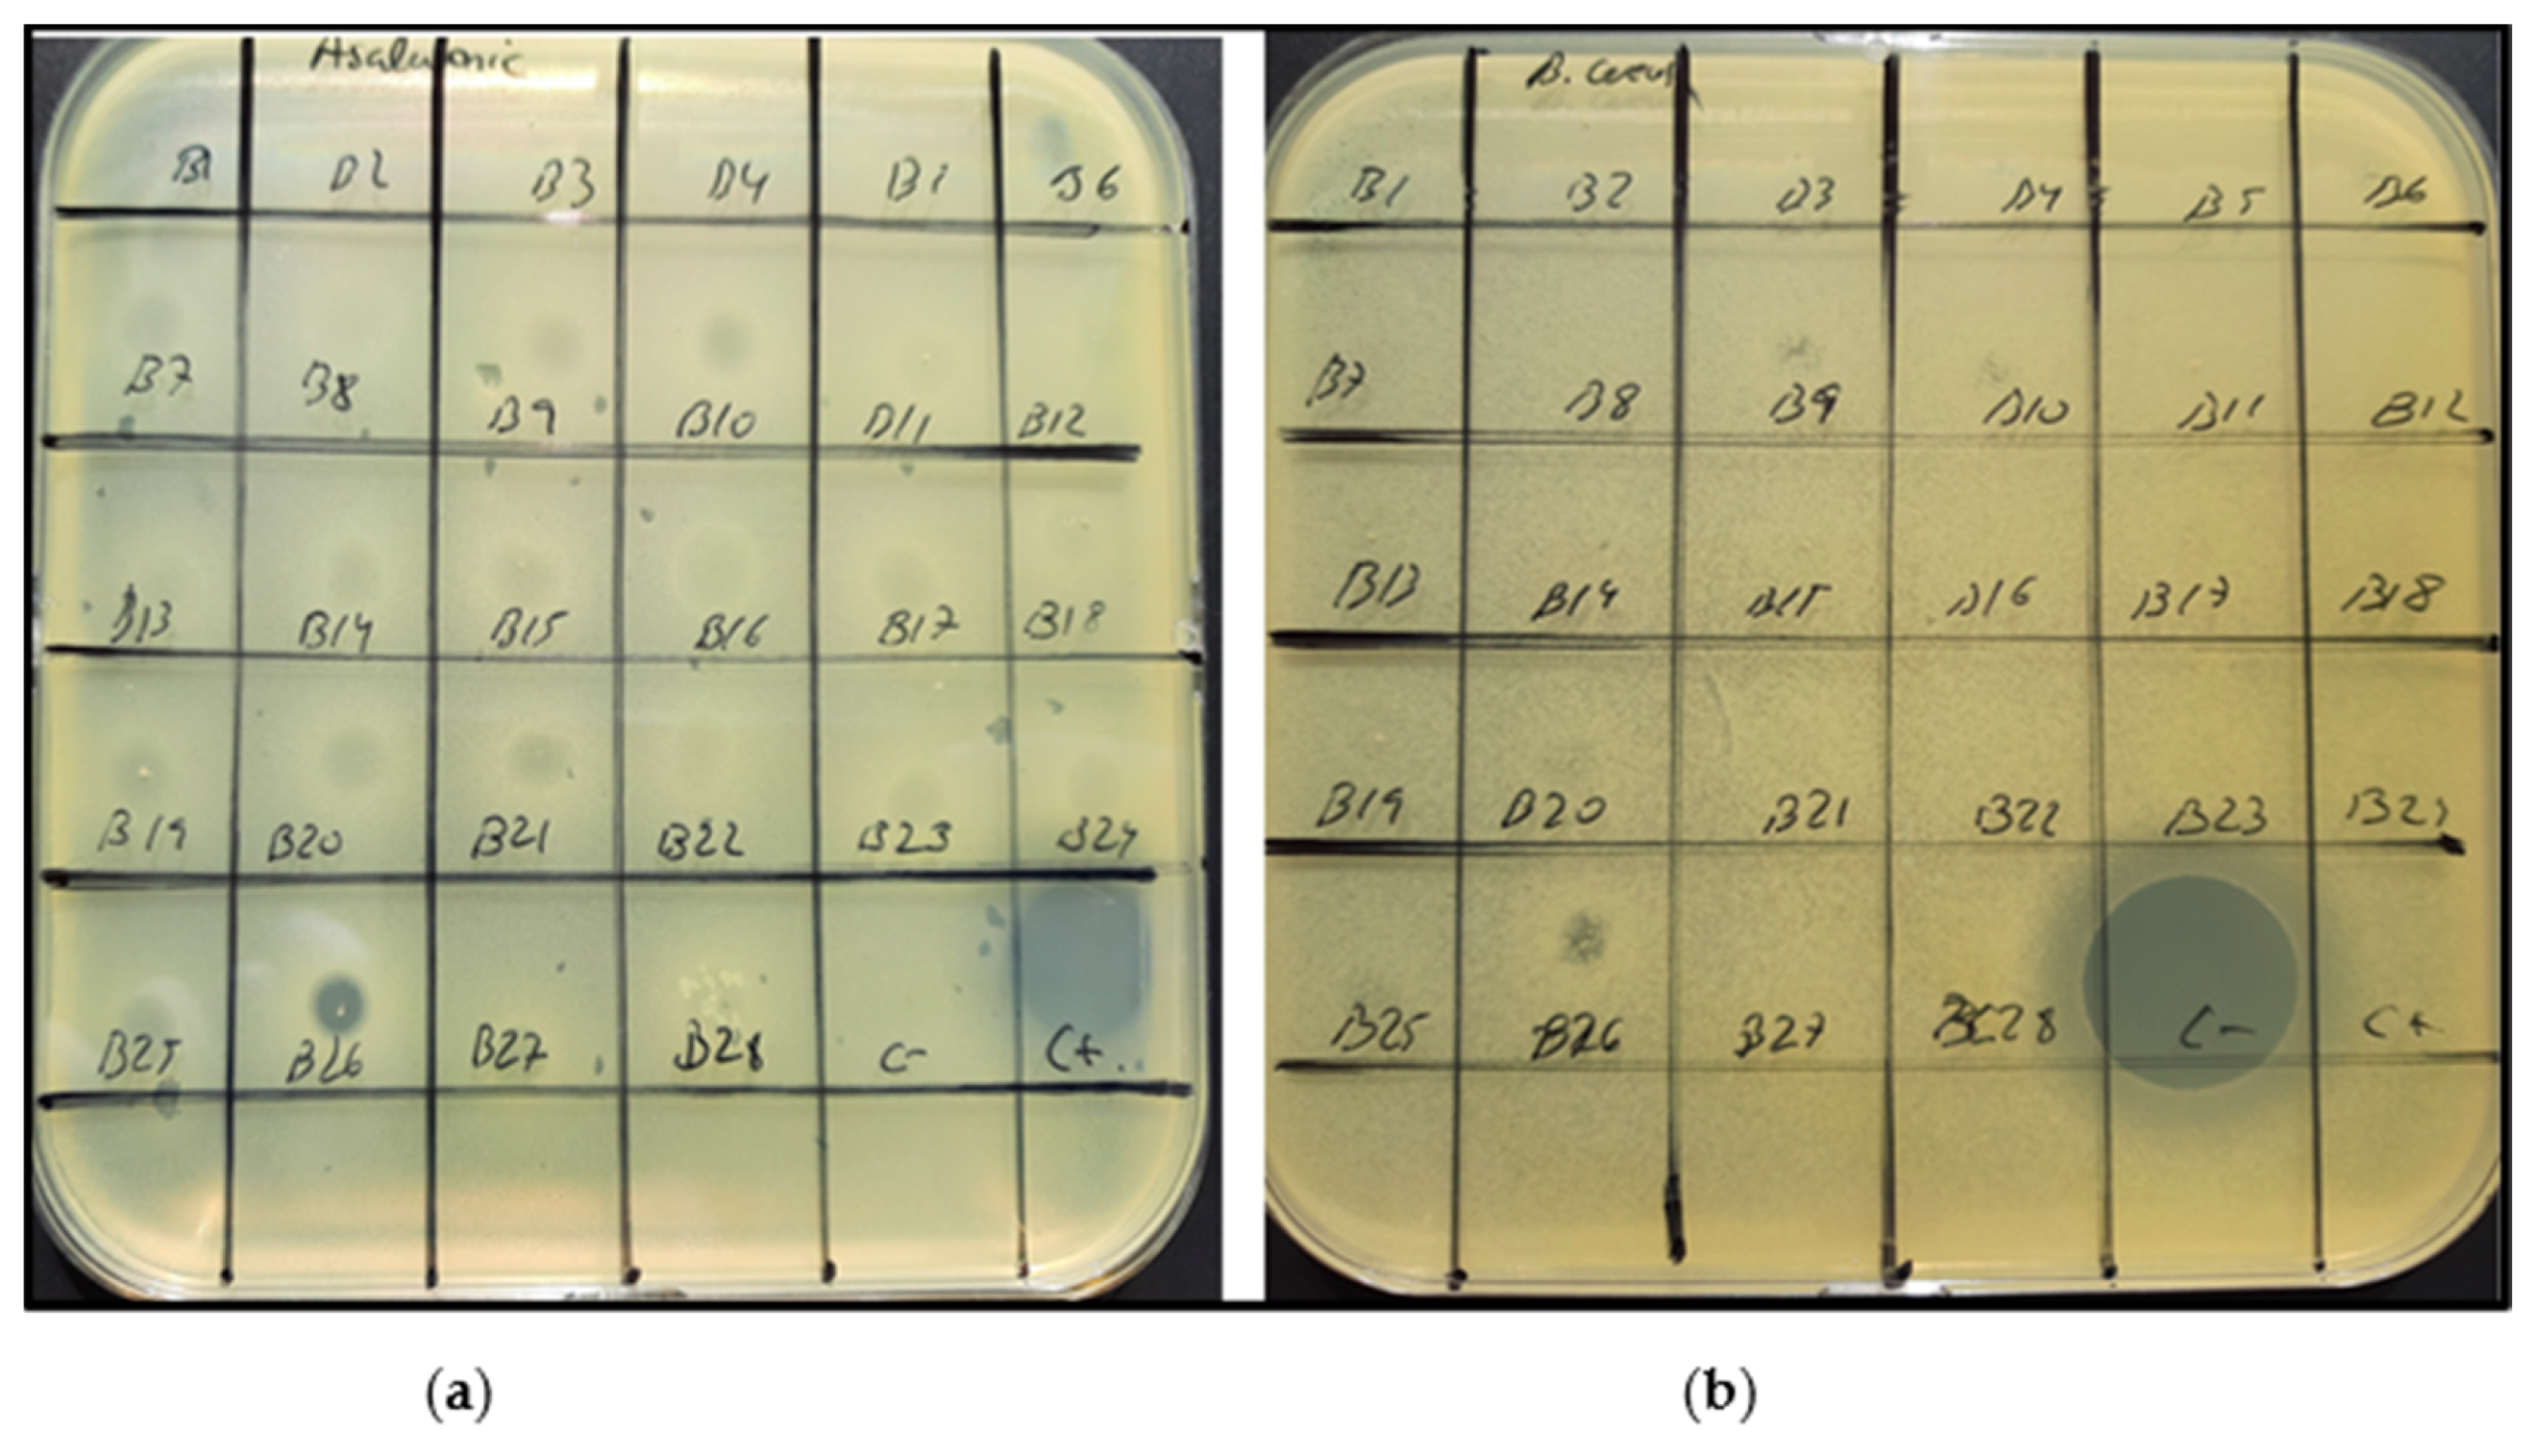
Sustainability 13 06520 g003

Valorisation of Brewer’s Spent Yeasts’ Hydrolysates as High-Value Bioactive Molecules
Abstract
1. Introduction
2. Materials and Methods
2.1. Raw Material
2.2. Hydrolysis Kinetics and Effectiveness of Proteolytic Activity
2.3. Analytical Determinations
2.4. Degree of Hydrolysis
2.5. Antioxidant Bioactivity Test
2.6. Anti-Microbial Bioactivity Tests
2.6.1. Microorganisms and Substrates
2.6.2. Agar Diffusion Method
2.6.3. MIC Assay
2.7. Parameter Optimization via Box–Behnken Design (BBD)
2.8. Statistical Analysis of the Model
3. Results
3.1. Parameter Optimization via Box–Behnken Design (BBD)
3.2. Anti-Microbial Bioactivity
3.2.1. Agar Diffusion Assay
3.2.2. MIC Assay
4. Discussion
4.1. Parameter Optimization via Box–Behnken Design (BBD)
4.2. Antioxidant Bioactivity
4.3. Anti-Microbial Bioactivity
5. Conclusions
Author Contributions
Funding
Institutional Review Board Statement
Informed Consent Statement
Acknowledgments
Conflicts of Interest
References
- EUROSTAT. Happy International Beer Day! Available online: https://ec.europa.eu/eurostat/web/products-eurostat-news/-/edn-20200807-1 (accessed on 5 May 2021).
- Bleoanca, I.; Bahrim, G.E. Overview on Brewing Yeast Stress Factors. Rom. Biotechnol. Lett. 2013, 18, 8559–8572. [Google Scholar]
- Mussatto, S.I. Brewer’s spent grain: A valuable feedstock for industrial applications. J. Sci. Food Agric. 2014, 94, 1264–1275. [Google Scholar] [CrossRef]
- Mussatto, S.I. Biotechnological Potential of Brewing Industry By-Products. In Biotechnology for Agro-Industrial Residues Utilisation: Utilisation of Agro-Residues; Singh nee’ Nigam, P., Pandey, A., Eds.; Springer: Dordrecht, The Netherlands, 2009; pp. 313–326. [Google Scholar]
- Verstrepen, K.J.; Derdelinckx, G.; Verachtert, H.; Delvaux, F.R. Yeast flocculation: What brewers should know. Appl. Microbiol. Biotechnol. 2003, 61, 197–205. [Google Scholar] [CrossRef]
- Hellborg, L.; Piškur, J. 7-Yeast Diversity in the Brewing Industry. In Beer in Health and Disease Prevention; Preedy, V.R., Ed.; Academic Press: San Diego, CA, USA, 2009; pp. 77–88. [Google Scholar]
- The Brewers of Europe. Guidance Note for Establishing BAT in the Brewing Industry. Available online: http://www.cerveceros.org/pdf/cbmcguidance-note.pdf (accessed on 16 February 2017).
- Mathias, T.; Alexandre, V.; Cammarota, M.; Mello, P.; Servulo, E. Characterization and determination of brewer’s solid wastes composition. J. Inst. Brew. 2015, 121. [Google Scholar] [CrossRef]
- Martins, Z.E.; Erben, M.; Gallardo, A.E.; Silva, R.; Barbosa, I.; Pinho, O.; Ferreira, I.M.P.L.V.O. Effect of spent yeast fortification on physical parameters, volatiles and sensorial characteristics of home-made bread. Int. J. Food Sci. Technol. 2015, 50, 1855–1863. [Google Scholar] [CrossRef]
- Fărcaş, A.; Socaci, S.; Mudura, E.; Francisc, D.; Vodnar, D.; Tofana, M.; Salanta, L.-C. Exploitation of Brewing Industry Wastes to Produce Functional Ingredients. In Brewing Technology; INTECH: London, UK, 2017; Available online: https://www.intechopen.com/books/brewing-technology/exploitation-of-brewing-industry-wastes-to-produce-functional-ingredients (accessed on 5 February 2021).
- Jaeger, A.; Arendt, E.K.; Zannini, E.; Sahin, A.W. Brewer’s Spent Yeast (BSY), an Underutilized Brewing By-Product. Fermentation 2020, 6, 123. [Google Scholar] [CrossRef]
- Tang, Z.; Cenkowski, S.; Muir, W.E. Modelling the Superheated-steam Drying of a Fixed Bed of Brewers’ Spent Grain. Biosyst. Eng. 2004, 87, 67–77. [Google Scholar] [CrossRef]
- Thiago, R.; Pedro, P.; Eliana, F.C.S.; Mathias, T.; Mello, P.; Sérvulo, E.F.C. Solid wastes in brewing process: A review. J. Brew. Distill. 2014, 5, 1–9. [Google Scholar] [CrossRef]
- Podpora, B.; Swiderski, F. Spent Brewer’s Yeast Autolysates as a New and Valuable Component of Functional Food and Dietary Supplements. J. Food Process. Technol. 2015, 6. [Google Scholar] [CrossRef]
- Yamada, E.; Sgarbieri, V. Yeast (Saccharomyces cerevisiae) Protein Concentrate: Preparation, Chemical Composition, and Nutritional and Functional Properties. J. Agric. Food Chem. 2005, 53, 3931–3936. [Google Scholar] [CrossRef]
- Yoshida, Y.; Yokoi, W.; Wada, Y.; Ohishi, K.; Ito, M.; Sawada, H. Potent Hypocholesterolemic Activity of the Yeast Kluyveromyces marxianus YIT 8292 in Rats Fed a High Cholesterol Diet. Biosci. Biotechnol. Biochem. 2004, 68, 1185–1192. [Google Scholar] [CrossRef]
- Chae, H.J.; Joo, H.; In, M.-J. Utilization of brewer’s yeast cells for the production of food-grade yeast extract. Part 1: Effects of different enzymatic treatments on solid and protein recovery and flavor characteristics. Bioresour. Technol. 2001, 76, 253–258. [Google Scholar] [CrossRef]
- Ferreira, I.M.P.L.V.O.; Pinho, O.; Vieira, E.; Tavarela, J.G. Brewer’s Saccharomyces yeast biomass: Characteristics and potential applications. Trends Food Sci. Technol. 2010, 21, 77–84. [Google Scholar] [CrossRef]
- San Martin, D.; Orive, M.; Iñarra, B.; Castelo, J.; Estévez, A.; Nazzaro, J.; Iloro, I.; Elortza, F.; Zufía, J. Brewers’ Spent Yeast and Grain Protein Hydrolysates as Second-Generation Feedstuff for Aquaculture Feed. Waste Biomass Valorization 2020, 11, 5307–5320. [Google Scholar] [CrossRef]
- EFSA. Scientific Opinion on the safety of ‘yeast beta-glucans’ as a Novel Food ingredient. EFSA J. 2011, 9. [Google Scholar] [CrossRef]
- Suphantharika, M.; Varavinit, S.; Shobsngob, S. Determination of Optimum Conditions for Autolyzed Yeast Extract Production. Asean J. Sci. Technol. Dev. 1997, 14, 21–28. [Google Scholar]
- Thammakiti, S.; Suphantharika, M.; Phaesuwan, T.; Verduyn, C. Preparation of spent brewer’s yeast β-glucans for potential applications in the food industry. Int. J. Food Sci. Technol. 2004, 39, 21–29. [Google Scholar] [CrossRef]
- Rumsey, G.L.; Hughes, S.; Kinsella, J. Use of Dietary Yeast Saccharomyces cerevisiae Nitrogen by Lake Trout. J. World Aquac. Soc. 2007, 21, 205–209. [Google Scholar] [CrossRef]
- Rumsey, G.L.; Kinsella, J.E.; Shetty, K.J.; Hughes, S.G. Effect of high dietary concentrations of brewer’s dried yeast on growth performance and liver uricase in rainbow trout (Oncorhynchus mykiss). Anim. Feed Sci. Technol. 1991, 33, 177–183. [Google Scholar] [CrossRef]
- Rumsey, G.L.; Winfree, R.A.; Hughes, S.G. Nutritional value of dietary nucleic acids and purine bases to rainbow trout (Oncorhynchus mykiss). Aquaculture 1992, 108, 97–110. [Google Scholar] [CrossRef]
- Podpora, B.; Swiderski, F.; Sadowska, A.; Rakowska, R.; Wasiak-Zys, G. Spent brewer’s yeast extracts as a new component of functional food. Czech. J. Food Sci. 2016, 34, 554–563. [Google Scholar] [CrossRef]
- Edozien, J.C.; Udo, U.U.; Young, V.R.; Scrimshaw, N.S. Effects of High Levels of Yeast Feeding on Uric Acid Metabolism of Young Men. Nature 1970, 228, 180. [Google Scholar] [CrossRef] [PubMed]
- Bekatorou, A.; Psarianos, C.; Koutinas, A. Production of Food Grade Yeasts. Food Technol. Biotechnol. 2006, 44, 407–415. [Google Scholar]
- Toldrá, F.; Reig, M.; Aristoy, M.C.; Mora, L. Generation of bioactive peptides during food processing. Food Chem. 2018, 267, 395–404. [Google Scholar] [CrossRef] [PubMed]
- Hou, Y.; Wu, Z.; Dai, Z.; Wang, G.; Wu, G. Protein hydrolysates in animal nutrition: Industrial production, bioactive peptides, and functional significance. J. Anim. Sci. Biotechnol. 2017, 8. [Google Scholar] [CrossRef]
- Huige, N.J. Brewery by-products and effluents. In Handbook of Brewing; Priest, F.G., Stewart, G.G., Eds.; CRC Press: Boca Raton, FL, USA, 2006; pp. 656–713. [Google Scholar]
- Halász, A.; Lásztity, R. Use of Yeast Biomass in Food Production; CRC Press: Boca Raton, FL, USA, 2017; pp. 1–312. [Google Scholar]
- Amorim, M.; Pereira, J.O.; Gomes, D.; Pereira, C.D.; Pinheiro, H.; Pintado, M. Nutritional ingredients from spent brewer’s yeast obtained by hydrolysis and selective membrane filtration integrated in a pilot process. J. Food Eng. 2016, 185, 42–47. [Google Scholar] [CrossRef]
- Vieira, E.F.; Carvalho, J.; Pinto, E.; Cunha, S.; Almeida, A.A.; Ferreira, I.M.P.L.V.O. Nutritive value, antioxidant activity and phenolic compounds profile of brewer’s spent yeast extract. J. Food Compos. Anal. 2016, 52, 44–51. [Google Scholar] [CrossRef]
- Silva Araújo, V.B.d.; Melo, A.N.F.d.; Costa, A.G.; Castro-Gomez, R.H.; Madruga, M.S.; Souza, E.L.d.; Magnani, M. Followed extraction of β-glucan and mannoprotein from spent brewer’s yeast (Saccharomyces uvarum) and application of the obtained mannoprotein as a stabilizer in mayonnaise. Innov. Food Sci. Emerg. Technol. 2014, 23, 164–170. [Google Scholar] [CrossRef]
- Jurczyńska, E.; Saczko, J.; Kulbacka, J.; Kawa-Rygielska, J.; Błażewicz, J. Beta-glucan as a natural anticancer agent. Pol. Merkur. Lek. Organ Pol. Tow. Lek. 2012, 33, 217–220. [Google Scholar]
- Nakamura, T.; Agata, K.; Mizutani, M.; Iino, H. Effects of brewer’s yeast cell wall on constipation and defecation in experimentally constipated rats. Biosci. Biotechnol. Biochem. 2001, 65, 774–780. [Google Scholar] [CrossRef]
- Suphantharika, M.; Khunrae, P.; Thanardkit, P.; Verduyn, C. Preparation of spent brewer’s yeast β-glucans with a potential application as an immunostimulant for black tiger shrimp, Penaeus monodon. Bioresour. Technol. 2003, 88, 55–60. [Google Scholar] [CrossRef]
- Jung, E.Y.; Lee, H.-S.; Choi, J.W.; Ra, K.S.; Kim, M.-R.; Suh, H.J. Glucose Tolerance and Antioxidant Activity of Spent Brewer’s Yeast Hydrolysate with a High Content of Cyclo-His-Pro (CHP). J. Food Sci. 2011, 76, C272–C278. [Google Scholar] [CrossRef]
- Callejón, R.M.; Rodríguez-Naranjo, M.I.; Ubeda, C.; Hornedo-Ortega, R.; Garcia-Parrilla, M.C.; Troncoso, A.M. Reported Foodborne Outbreaks Due to Fresh Produce in the United States and European Union: Trends and Causes. Foodborne Pathog. Dis. 2015, 12, 32–38. [Google Scholar] [CrossRef] [PubMed]
- Gyawali, R.; Ibrahim, S.A. Natural products as antimicrobial agents. Food Control 2014, 46, 412–429. [Google Scholar] [CrossRef]
- Hermansen, K.; Søndergaard, M.; Høie, L.; Carstensen, M.; Brock, B. Beneficial Effects of a Soy-Based Dietary Supplement on Lipid Levels and Cardiovascular Risk Markers in Type 2 Diabetic Subjects. Diabetes Care 2001, 24, 228–233. [Google Scholar] [CrossRef] [PubMed]
- Jenkins, D.J.; Kendall, C.W.; Jackson, C.-J.C.; Connelly, P.W.; Parker, T.; Faulkner, D.; Vidgen, E.; Cunnane, S.C.; Leiter, L.A.; Josse, R.G. Effects of high- and low-isoflavone soyfoods on blood lipids, oxidized LDL, homocysteine, and blood pressure in hyperlipidemic men and women. Am. J. Clin. Nutr. 2002, 76, 365–372. [Google Scholar] [CrossRef] [PubMed]
- AOAC INTERNATIONAL Officers and Committees: 1995. J. AOAC Int. 2020, 78, 253–283. [CrossRef]
- Nielsen, P.; Petersen, D.; Dambmann, C. Improved Method for Determining Food Protein Degree of Hydrolysis. J. Food Sci. 2001, 66. [Google Scholar] [CrossRef]
- Sillero Ortigosa, L.; Prado, R.; Labidi, J. Optimization of Different Extraction Methods to Obtaining Bioactive Compounds from Larix Decidua Bark. Chem. Eng. Trans. 2018, 70, 1369–1374. [Google Scholar]
- Bougherra, F.; Abdelkader, D.B.; Balti, R.; Przybylski, R.; Adoui, F.; Elhameur, H.; Chevalier, M.; Flahaut, C.; Dhulster, P.; Naima, N. Antibacterial activity of new peptide from bovine casein hydrolyzed by a serine metalloprotease of Lactococcus lactis subsp lactis BR16. J. Funct. Foods 2017, 32, 112–122. [Google Scholar] [CrossRef]
- Zambrano, C.; Kerekes, E.B.; Kotogán, A.; Papp, T.; Vágvölgyi, C.; Krisch, J.; Takó, M. Antimicrobial activity of grape, apple and pitahaya residue extracts after carbohydrase treatment against food-related bacteria. LWT 2019, 100, 416–425. [Google Scholar] [CrossRef]
- Ahmad, A.; Rehman, M.U.; Wali, A.F.; El-Serehy, H.A.; Al-Misned, F.A.; Maodaa, S.N.; Aljawdah, H.M.; Mir, T.M.; Ahmad, P. Box–Behnken Response Surface Design of Polysaccharide Extraction from Rhododendron arboreum and the Evaluation of Its Antioxidant Potential. Molecules 2020, 25, 3835. [Google Scholar] [CrossRef]
- Ashok, A.; Kumar, D. Different methodologies for sustainability of optimization techniques used in submerged and solid state fermentation. 3 Biotech. 2017, 7, 301. [Google Scholar] [CrossRef] [PubMed]
- Amorim, M.; Pinheiro, H.; Pintado, M. Valorization of spent brewer’s yeast: Optimization of hydrolysis process towards the generation of stable ACE-inhibitory peptides. LWT 2019, 111, 77–84. [Google Scholar] [CrossRef]
- Marson, G.V.; de Castro, R.J.S.; Machado, M.T.d.C.; da Silva Zandonadi, F.; Barros, H.D.d.F.Q.; Maróstica Júnior, M.R.; Sussulini, A.; Hubinger, M.D. Proteolytic enzymes positively modulated the physicochemical and antioxidant properties of spent yeast protein hydrolysates. Process Biochem. 2020, 91, 34–45. [Google Scholar] [CrossRef]
- Tagliazucchi, D.; Verzelloni, E.; Conte, A. Effect of Dietary Melanoidins on Lipid Peroxidation during Simulated Gastric Digestion: Their Possible Role in the Prevention of Oxidative Damage. J. Agric. Food Chem. 2010, 58, 2513–2519. [Google Scholar] [CrossRef]
- Karmoker, J.R.; Hasan, I.; Ahmed, N.; Saifuddin, M.; Reza, M. Development and Optimization of Acyclovir Loaded Mucoadhesive Microspheres by Box -Behnken Design. Dhaka Univ. J. Pharm. Sci. 2019, 18. [Google Scholar] [CrossRef]
- Christensen, R. Analysis of Variance, Design, and Regression. Linear Modeling for Unbalanced Data, 2nd ed.; Chapman and Hall/CRC: London, UK, 2016. [Google Scholar]
- Marson, G.V.; Machado, M.T.d.C.; de Castro, R.J.S.; Hubinger, M.D. Sequential hydrolysis of spent brewer’s yeast improved its physico-chemical characteristics and antioxidant properties: A strategy to transform waste into added-value biomolecules. Process Biochem. 2019, 84, 91–102. [Google Scholar] [CrossRef]
- Nahar, M.; Zakaria, Z.; Hashim, U.; Bari, M. Effect of pH and Salt Concentration on Protein Solubility of Slaughtered and Non-Slaughtered Broiler Chicken Meat. Sains Malays. 2017, 46, 719–724. [Google Scholar] [CrossRef]
- Bougatef, A.; Nedjar-Arroume, N.; Ravallec-Plé, R.; Leroy, Y.; Guillochon, D.; Barkia, A.; Nasri, M. Angiotensin I-converting enzyme (ACE) inhibitory activities of sardinelle (Sardinella aurita) by-products protein hydrolysates obtained by treatment with microbial and visceral fish serine proteases. Food Chem. 2008, 111, 350–356. [Google Scholar] [CrossRef]
- Ishak, N.H.; Sarbon, N.M. Optimization of the enzymatic hydrolysis conditions of waste from shortfin scad (Decapterus Macrosoma) for the production of angiotensin I-converting enzyme (ACE) inhibitory peptide using response surface methodology. Int. Food Res. J. 2017, 24, 1735–1743. [Google Scholar]
- Novozymes S/A, Alcalase™, Protamex™ Product Sheet. 2002. Numbers: 2001-08281-02. Available online: https://biosolutions.novozymes.com/en/animal-protein/products/alcalase (accessed on 3 May 2021).
- Novozymes S/A, Flavourzyme™ Product Sheet. 2002. Numbers: 2001-08282-02. Available online: https://biosolutions.novozymes.com/en/animal-protein/products/flavourzyme (accessed on 3 May 2021).
- Novozymes S/A, Protamex™ Product Sheet. 2002. Numbers: 2001-08284-02. Available online: https://biosolutions.novozymes.com/en/animal-protein/products/protamex (accessed on 3 May 2021).
- Phanturat, P.; Benjakul, S.; Visessanguan, W.; Roytrakul, S. Use of pyloric caeca extract from bigeye snapper (Priacanthus macracanthus) for the production of gelatin hydrolysate with antioxidative activity. LWT Food Sci. Technol. 2010, 43, 86–97. [Google Scholar] [CrossRef]
- Raghavan, S.; Kristinsson, H.; Leeuwenburgh, C. Radical Scavenging and Reducing Ability of Tilapia (Oreochromis niloticus) Protein Hydrolysates. J. Agric. Food Chem. 2008, 56, 10359–10367. [Google Scholar] [CrossRef] [PubMed]
- Lei, J.; Sun, L.; Huang, S.; Zhu, C.; Li, P.; He, J.; Mackey, V.; Coy, D.H.; He, Q. The antimicrobial peptides and their potential clinical applications. Am. J. Transl. Res. 2019, 11, 3919–3931. [Google Scholar]
- Sampedro, J.; Valdivia, E.R. New Antimicrobial Agents of Plant Origin. In Antimicrobial Compounds: Current Strategies and New Alternatives; Villa, T.G., Veiga-Crespo, P., Eds.; Springer: Berlin/Heidelberg, Germany, 2014; pp. 83–114. [Google Scholar]
- Böhme, K.; Barros-Velázquez, J.; Calo-Mata, P.; Aubourg, S.P. Antibacterial, Antiviral and Antifungal Activity of Essential Oils: Mechanisms and Applications. In Antimicrobial Compounds: Current Strategies and New Alternatives; Villa, T.G., Veiga-Crespo, P., Eds.; Springer: Berlin/Heidelberg, Germany, 2014; pp. 51–81. [Google Scholar]
- Li, L.; Zong, X.; Zhang, J.; Wei, C.; Huang, Z.; Luo, H. Antibacterial Activity of Brewer’s Spent Grains Peptides to Staphylococcus aureus. Adv. Mater. Res. 2013, 699, 320–325. [Google Scholar] [CrossRef]
- Liu, Z.; Brady, A.; Young, A.; Rasimick, B.; Chen, K.; Zhou, C.; Kallenbach, N.R. Length Effects in Antimicrobial Peptides of the (RW)n Series. Antimicrob. Agents Chemother. 2007, 51, 597. [Google Scholar] [CrossRef]
- Harlow, B.; Bryant, R.; Cohen, S.; O’Connell, S.; Flythe, M. Degradation of spent craft brewer’s yeast by caprine rumen hyper ammonia-producing bacteria. Lett. Appl. Microbiol. 2016, 63. [Google Scholar] [CrossRef]
- Bryant, R.; Cohen, S. Characterization of Hop Acids in Spent Brewer’s Yeast from Craft and Multinational Sources. J. Am. Soc. Brew. Chem. 2015, 73, 159–164. [Google Scholar] [CrossRef]
- Bartmańska, A.; Wałecka-Zacharska, E.; Tronina, T.; Popłoński, J.; Sordon, S.; Brzezowska, E.; Bania, J.; Huszcza, E. Antimicrobial Properties of Spent Hops Extracts, Flavonoids Isolated Therefrom, and Their Derivatives. Molecules 2018, 23, 2059. [Google Scholar] [CrossRef] [PubMed]
- Pszczolkowski, V.; Bryant, R.; Harlow, B.; Aiken, G.; Martin, L.; Flythe, M. Effects of Spent Craft Brewers’ Yeast on Fermentation and Methane Production by Rumen Microorganisms. Adv. Microbiol. 2016, 06, 716–723. [Google Scholar] [CrossRef]

| Independent Variable | Symbol | Coded Factor | ||
|---|---|---|---|---|
| Coded | −1 | 0 | 1 | |
| Enzyme–substrate ratio (%) | A | 0.030 | 0.075 | 0.120 |
| Hydrolysis time (minutes) | B | 2 | 5 | 8 |
| Temperature (°C) | C | 40.0 | 47.5 | 55.0 |
| pH | D | 4.10 | 5.05 | 6.00 |
| Run | Enzyme–Substrate Ratio (%) | Time (hours) | Temperature (°C) | pH | PEY (%) | DH (% Tf − T0) in the Sample | Antioxidant Activity (g TEAC) | |||
|---|---|---|---|---|---|---|---|---|---|---|
| Observed | Predicted | Observed | Predicted | Observed | Predicted | |||||
| 1 | 0.075 | 5 | 55.0 | 6.00 | 29.44 | 29.40 | 32.15 | 30.42 | 1.62 | 1.39 |
| 2 | 0.120 | 5 | 47.5 | 6.00 | 29.67 | 27.46 | 28.88 | 31.59 | 1.59 | 1.42 |
| 3 | 0.030 | 2 | 47.5 | 5.05 | 13.72 | 12.24 | 10.30 | 9.37 | 0.80 | 0.73 |
| 4 | 0.075 | 2 | 47.5 | 4.10 | 13.90 | 14.87 | 6.30 | 8.03 | 0.65 | 0.67 |
| 5 | 0.120 | 8 | 47.5 | 5.05 | 25.20 | 25.68 | 35.43 | 34.19 | 1.43 | 1.39 |
| 6 | 0.075 | 8 | 47.5 | 4.10 | 19.85 | 19.01 | 23.02 | 22.00 | 1.11 | 1.03 |
| 7 | 0.075 | 5 | 47.5 | 5.05 | 19.14 | 18.96 | 21.81 | 19.53 | 1.01 | 1.06 |
| 8 | 0.075 | 8 | 47.5 | 6.00 | 29.00 | 28.99 | 35.71 | 35.67 | 1.47 | 1.46 |
| 9 | 0.120 | 5 | 47.5 | 4.10 | 19.52 | 20.22 | 22.24 | 22.96 | 1.01 | 0.99 |
| 10 | 0.075 | 5 | 40.0 | 4.10 | 19.19 | 18.60 | 12.35 | 13.28 | 0.79 | 0.74 |
| 11 | 0.030 | 5 | 40.0 | 5.05 | 16.25 | 15.03 | 16.00 | 15.75 | 0.97 | 0.81 |
| 12 | 0.030 | 5 | 55.0 | 5.05 | 18.37 | 18.59 | 12.85 | 12.46 | 1.01 | 1.03 |
| 13 | 0.075 | 2 | 55.0 | 5.05 | 17.51 | 18.43 | 12.11 | 14.27 | 0.90 | 0.99 |
| 14 | 0.030 | 8 | 47.5 | 5.05 | 17.41 | 19.13 | 18.37 | 18.84 | 0.95 | 1.10 |
| 15 | 0.075 | 5 | 47.5 | 5.05 | 19.57 | 18.96 | 18.37 | 19.53 | 0.48 | 1.06 |
| 16 | 0.030 | 5 | 47.5 | 6.00 | 20.03 | 20.90 | 23.23 | 25.79 | 1.23 | 1.13 |
| 17 | 0.075 | 8 | 40.0 | 5.05 | 21.78 | 21.75 | 23.44 | 24.78 | 1.13 | 1.13 |
| 18 | 0.075 | 5 | 47.5 | 5.05 | 19.19 | 18.96 | 18.09 | 19.53 | 1.09 | 1.06 |
| 19 | 0.120 | 5 | 55.0 | 5.05 | 25.61 | 25.25 | 28.88 | 30.05 | 1.26 | 1.32 |
| 20 | 0.075 | 2 | 40.0 | 5.05 | 15.17 | 14.87 | 12.07 | 10.81 | 0.79 | 0.77 |
| 21 | 0.075 | 5 | 55.0 | 4.10 | 17.76 | 17.53 | 19.68 | 16.74 | 1.05 | 0.96 |
| 22 | 0.075 | 8 | 55.0 | 5.05 | 25.71 | 25.31 | 28.30 | 28.24 | 1.35 | 1.36 |
| 23 | 0.120 | 2 | 47.5 | 5.05 | 19.78 | 18.8 | 18.35 | 15.71 | 1.15 | 1.02 |
| 24 | 0.075 | 2 | 47.5 | 6.00 | 17.56 | 19.36 | 21.32 | 21.70 | 0.94 | 1.09 |
| 25 | 0.120 | 5 | 40.0 | 5.05 | 19.03 | 21.59 | 18.54 | 19.85 | 1.04 | 1.10 |
| 26 | 0.030 | 5 | 47.5 | 4.10 | 13.68 | 13.66 | 6.50 | 7.07 | 0.78 | 0.70 |
| 27 | 0.075 | 5 | 40.0 | 6.00 | 21.62 | 21.21 | 30.83 | 26.96 | 1.11 | 1.16 |
| 28 (CTR) | - | 5 | 47.5 | 5.05 | 13.10 | 10.24 | 0.57 | |||
| Coefficients | p-Value | |||||
|---|---|---|---|---|---|---|
| PEY (%) | DH (% Tf − T0) in the Sample | Antioxidant Activity (g TEAC) | PEY (%) | DH (% Tf − T0) in the Sample | Antioxidant Activity (g TEAC) | |
| Intercept | 157.5190 | 36.6557 | −1.3415 | |||
| A:Enzyme | 72.8704 | −139.3920 | 3.2222 | <0.0001 | <0.0001 | 0.0050 |
| B:Time | −1.2845 | 1.0768 | 0.06139 | <0.0001 | <0.0001 | 0.0007 |
| C:Temperature | −3.3014 | −0.5185 | 0.0151 | 0.0001 | 0.0092 | 0.0234 |
| D:pH | −31.8913 | −14.3639 | 0.2254 | <0.0001 | <0.0001 | 0.0001 |
| AB | 16.6866 | 0.0417 | ||||
| AC | 9.9882 | 0.0041 | ||||
| AD | −59.0043 | 0.0245 | ||||
| BC | ||||||
| BD | 0.4816 | 0.0403 | ||||
| CD | 0.3246 | 0.0016 | ||||
| AA | ||||||
| BB | ||||||
| CC | 0.0200 | 0.0343 | ||||
| DD | 1.7699 | 2.5728 | 0.0044 | 0.0092 | ||
| R2 | 94.89 | 95.63 | 70.46 | |||
| Adj R2 | 92.62 | 93.69 | 65.09 | |||
| p-Value | |||
|---|---|---|---|
| PEY (%) | DH (% Tf − T0) in the SAMPLE | Antioxidant Activity (g TEAC) | |
| A:Enzyme | 0.0004 | 0.0120 | 0.2690 |
| B:Time | 0.0004 | 0.0073 | 0.1942 |
| C:Temperature | 0.0015 | 0.1017 | 0.3580 |
| D:pH | 0.0004 | 0.0076 | 0.1546 |
| AB | 0.1618 | ||
| AC | 0.0830 | ||
| AD | 0.1354 | ||
| BC | |||
| BD | 0.0073 | ||
| CD | 0.0026 | ||
| AA | |||
| BB | |||
| CC | 0.0068 | ||
| DD | 0.0034 | 0.1017 | |
| Lack of fit test | 0.0314 | 0.6173 | 0.9922 |
| Hydrolysates | Staphylococcus aureus | Salmonella enterica | Escherichia coli | Bacillus subtilis | Aeromonas salmonicida | Bacillus cereus |
|---|---|---|---|---|---|---|
| 1 | NI | NI | NI | NI | + | NI |
| 2 | NI | NI | NI | NI | NI | NI |
| 3 | NI | NI | NI | NI | + | NI |
| 4 | NI | NI | NI | NI | + | + |
| 5 | NI | NI | NI | NI | + | NI |
| 6 | NI | NI | NI | NI | ++ | + |
| 7 | NI | NI | NI | NI | + | NI |
| 8 | NI | NI | NI | NI | NI | NI |
| 9 | NI | + | NI | + | +++ | + |
| 10 | NI | + | NI | + | +++ | + |
| 11 | NI | NI | NI | NI | ++ | NI |
| 12 | NI | NI | NI | NI | + | NI |
| 13 | NI | NI | NI | NI | ++ | NI |
| 14 | NI | NI | NI | NI | ++ | NI |
| 15 | NI | NI | NI | NI | +++ | NI |
| 16 | NI | NI | NI | NI | ++ | NI |
| 17 | NI | NI | NI | NI | ++ | NI |
| 18 | NI | NI | NI | NI | + | NI |
| 19 | NI | NI | NI | NI | ++ | NI |
| 20 | NI | NI | NI | + | +++ | + |
| 21 | NI | NI | NI | NI | +++ | NI |
| 22 | NI | NI | NI | NI | ++ | NI |
| 23 | NI | NI | NI | NI | ++ | NI |
| 24 | NI | NI | NI | NI | ++ | NI |
| 25 | NI | NI | NI | NI | ++ | NI |
| 26 | NI | NI | NI | + | +++ | + |
| 27 | NI | NI | NI | NI | ++ | NI |
| CTR | NI | NI | NI | NI | + | NI |
| Sodium phosphate buffer 0.01 M pH 7.5 | NI | NI | NI | NI | NI | NI |
| Gentamicin 2 mg/mL | ++++ | ++++ | ++++ | ++++ | ++++ | ++++ |
| Hydrolysates | MIC (mg/mL) | |||
|---|---|---|---|---|
| Salmonella enterica | Bacillus subtilis | Bacillus cereus | Aeromonas salmonicida | |
| 1 | - | - | - | 50 |
| 3 | - | - | - | 50 |
| 4 | - | - | 25 | 25 |
| 5 | - | - | - | 50 |
| 6 | - | - | 25 | 25 |
| 7 | - | - | - | 50 |
| 9 | 50 | 50 | 25 | 25 |
| 10 | 50 | 50 | 25 | 6.25–12.5 |
| 11 | - | - | - | 50 |
| 12 | - | - | - | 50 |
| 13 | - | - | - | 50 |
| 14 | - | - | - | 50 |
| 15 | - | - | - | 50 |
| 16 | - | - | - | >50 |
| 17 | - | - | - | 50 |
| 18 | - | - | - | >50 |
| 19 | - | - | - | 50 |
| 20 | - | 50 | 50 | 25 |
| 21 | - | - | - | 50 |
| 22 | - | - | - | 50 |
| 23 | - | - | - | 50 |
| 24 | - | - | - | 50 |
| 25 | - | - | - | 50 |
| 26 | - | 50 | 25 | 25 |
| 27 | - | - | - | 50 |
| 28 (CTR) | - | - | - | 50 |
Publisher’s Note: MDPI stays neutral with regard to jurisdictional claims in published maps and institutional affiliations. |
© 2021 by the authors. Licensee MDPI, Basel, Switzerland. This article is an open access article distributed under the terms and conditions of the Creative Commons Attribution (CC BY) license (https://creativecommons.org/licenses/by/4.0/).
Share and Cite
San Martin, D.; Ibarruri, J.; Iñarra, B.; Luengo, N.; Ferrer, J.; Alvarez-Ossorio, C.; Bald, C.; Gutierrez, M.; Zufía, J. Valorisation of Brewer’s Spent Yeasts’ Hydrolysates as High-Value Bioactive Molecules. Sustainability 2021, 13, 6520. https://doi.org/10.3390/su13126520
San Martin D, Ibarruri J, Iñarra B, Luengo N, Ferrer J, Alvarez-Ossorio C, Bald C, Gutierrez M, Zufía J. Valorisation of Brewer’s Spent Yeasts’ Hydrolysates as High-Value Bioactive Molecules. Sustainability. 2021; 13(12):6520. https://doi.org/10.3390/su13126520
Chicago/Turabian StyleSan Martin, David, Jone Ibarruri, Bruno Iñarra, Nagore Luengo, Jorge Ferrer, Carmen Alvarez-Ossorio, Carlos Bald, Monica Gutierrez, and Jaime Zufía. 2021. "Valorisation of Brewer’s Spent Yeasts’ Hydrolysates as High-Value Bioactive Molecules" Sustainability 13, no. 12: 6520. https://doi.org/10.3390/su13126520
APA StyleSan Martin, D., Ibarruri, J., Iñarra, B., Luengo, N., Ferrer, J., Alvarez-Ossorio, C., Bald, C., Gutierrez, M., & Zufía, J. (2021). Valorisation of Brewer’s Spent Yeasts’ Hydrolysates as High-Value Bioactive Molecules. Sustainability, 13(12), 6520. https://doi.org/10.3390/su13126520








